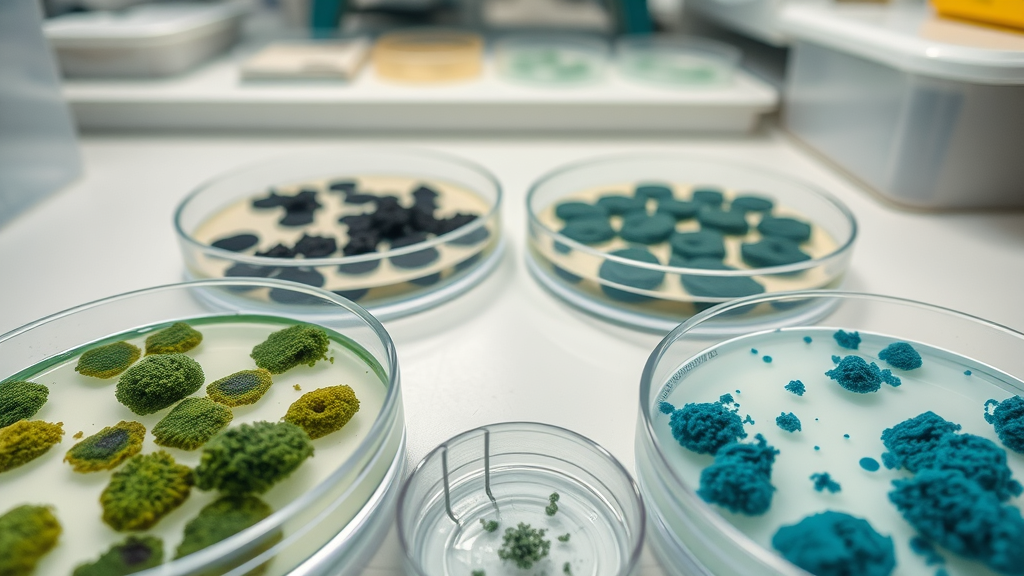
Multiple types of mold colonies—distinct green, black, and blue textures—in a laboratory setting, showing the diversity of mold that grows after water damage

Have you ever wondered how quickly mold can spread through your home after water damage—and what you can do to stop it before it causes health and property problems? If you’re worried about musty odors, visible stains, or the hidden hazards that follow leaks, flooding, or moisture in Lexington, SC, read on. This comprehensive guide will arm you with the knowledge you need to act fast and protect your family, your investment, and your peace of mind. Don’t let a small water leak turn into a big mold headache!
Are You Prepared for Mold Growth After Water Damage in Lexington, SC?
Mold growth after water damage is a common and sometimes underestimated threat for Lexington, SC homeowners. The region’s humidity, sudden storms, and plumbing unpredictabilities make water leaks or flooding more than a mere inconvenience—they’re prime triggers for rapid mold to grow in your home. Most residents aren’t prepared for how little time it takes for indoor mold to become a big problem; in as little as 24 to 48 hours, mold spores can multiply invisibly behind walls, under carpets, or in your attic. When water-soaked materials like drywall, insulation, or ceiling tiles are left damp—even briefly—mold grows fast enough to impact indoor air quality and threaten your family’s health, often before you spot the first patch.
Most homeowners don’t notice mold until it becomes a major problem, and after water damage, time is critical.” – Palmetto Mold Experts
Are you confident you can catch the signs of mold before they escalate? Do you know how to prevent mold growth from taking over after a water leak? From identifying mold problems early to choosing effective mold remediation, this expert-backed guide provides everything you need to take control after water damage in Lexington, SC.
What You’ll Learn About Mold Growth After Water Damage
- Why mold grows after water damage
- How to spot mold early
- Effective mold remediation solutions
- Best ways to prevent mold growth
- Key signs of mold problems to watch for
Understanding Mold Growth After Water Damage

Why Does Mold Grow After Water Damage?
When water seeps into your home—from a storm, flood, burst pipe, or even a minor water leak—it creates the perfect environment for mold growth. Mold spores are always present in the air, but they only begin to colonize when they land on moist organic material and have a steady food source. Materials like wood, drywall, carpet, and insulation absorb water and don’t dry quickly, providing an ideal substrate for mold to grow. Humidity levels above 60% turbocharge this process, making the aftermath of water damage a race against time. The affected area can become a breeding ground for various types of mold colonies, especially if repairs are delayed.
While it may seem harmless at first, unchecked moisture allows mold to grow in hidden spaces, causing more severe mold damage and impacting your indoor air quality. Mold growth after water damage isn’t just unsightly—it can worsen health effects like asthma attacks or allergic reactions and, if allowed to spread, lead to costly damage restoration. Fast, decisive action is critical. If you notice moisture, musty smells, or discoloration anywhere in your home, you may be witnessing the early stages of a mold problem that requires immediate attention.
The Link Between Water Leak and Mold Growth
The connection between a water leak and mold growth couldn’t be clearer. Even a small or hidden leak from a roof, pipe, appliance, or wall can provide enough moisture for mold to thrive. Unlike flooding, which is obvious, slow leaks might go unnoticed for weeks or even months. During that time, mold grows beneath surfaces, behind baseboards, or in ceiling tile layers, far from your daily view. This hidden mold can silently cause significant mold damage, eating away at surfaces and releasing spores that degrade indoor air quality.
Once the source of water is established, it’s important to halt the leak, dry the affected area completely, and monitor humidity levels closely. If not, you could end up not only with visible mold but also with a widespread mold infestation that extends well beyond the initial point of water damage. Leaks near HVAC or under flooring can be especially tough to detect, making regular inspections essential for effective prevention and early remediation.
Signs of Mold Growth After Water Damage
Recognizing the earliest signs of mold growth after water damage is vital to stopping a minor issue from escalating. The most common signs include a persistent musty or earthy odor, discoloration or staining on ceilings, walls, and floors, and the appearance of fuzzy, dark, or brightly colored patches—even if they’re small. Mold can also show up as black, green, blue, or white spots in damp corners, on window sills, or behind furniture. Sometimes, signs of mold are more subtle: peeling paint, warped wood, or increased allergy symptoms like sneezing and coughing among family members can suggest mold growing even if it’s not immediately visible.
In homes with recent water damage, keep a close eye on bathrooms, basements, kitchens, and areas near pipes, since these are most likely to harbor mold. Mold grows aggressively in areas that stay damp or lack proper ventilation. Early detection allows for a targeted response, so if you notice any of these warning signs, do not ignore them—a rapid response is the best way to prevent an expensive mold remediation job down the line.
| Common Types of Mold Found After Water Damage | Typical Signs | Areas Most Affected |
|---|---|---|
| Aspergillus | Musty odor, discoloration | Ceilings, walls, insulation |
| Penicillium | Blue-green spots, musty smell | Carpets, wallpaper, HVAC |
| Stachybotrys (Black Mold) | Slimy dark patches | Wood, drywall, basements |
How Fast Can Mold Grow After Water Damage?

Timeline for Mold to Grow After a Water Leak
Many homeowners in Lexington, SC are shocked to learn just how quickly mold can grow after water damage. The clock starts ticking immediately after a leak or flood—mold growth can begin within 24 to 48 hours. That means if you experience a burst pipe, washing machine overflow, or roof leak, you have a very short window to dry out the area and prevent mold damage before a significant problem arises. Within three days, visible mold colonies can appear and start spreading across the affected area, making cleanup more difficult and expensive the longer you wait.
This rapid timeline means that any delay—waiting until the weekend, skipping a professional inspection, or not thoroughly drying damp spots—might lead to extensive mold infestation. Once mold gains a foothold, it sends out spores to colonize new damp areas, which can quickly include much more than the original point of water damage. Fast action is necessary: extract water, dehumidify, and monitor hidden spaces for early signs of mold to grow.
Critical Factors for Rapid Mold Growth
Several key factors influence how quickly mold grows after water damage. Humidity levels above 60% are a major trigger. Poor ventilation, dark and enclosed spaces, and the presence of organic material like wood, drywall, or carpeting all contribute to a faster mold to grow cycle. Hidden leaks—such as those behind walls or under bathroom floors—are especially risky, as they provide a stable environment for mold to flourish undetected. In Lexington, SC, seasonal storms and humidity can create lingering dampness, meaning every homeowner is at risk after heavy rain.
The rate of mold growth is also impacted by how much standing water is left, how quickly drying begins, and whether contaminated or porous materials (like ceiling tiles, cardboard, or fabric) are promptly removed. Mold grows best where cleaning and monitoring are neglected, so maintaining a regular maintenance schedule is essential for prevent mold. By understanding these critical factors, you’ll be more equipped to act quickly and reduce the likelihood of a costly and dangerous mold problem developing in your home.
Types of Mold That Grow After Water Damage
Identifying Different Types of Mold
Not all mold is the same. After water damage, it’s common to find several types of mold in a single affected area, each posing unique risks. Aspergillus often appears as a powdery or fuzzy patch ranging from gray to green; it can trigger allergic reactions or respiratory issues, especially in those with compromised immune systems. Penicillium has a blue or blue-green color and tends to spread quickly across water-damaged carpeting or wallpaper, sometimes releasing musty odors. The most notorious, Stachybotrys—commonly known as black mold—is dark, slimy, and can produce toxins that cause more severe health effects.
Proper identification matters because some species are more aggressive or hazardous than others, influencing which mold remediation methods should be used. Mold grows in a variety of colors and textures, but any visible or suspected growth after water damage should be treated seriously and investigated by professionals who can distinguish the exact strain and recommend targeted removal strategies. Trying to identify and treat these varieties without experience can leave behind sources for the mold to regrow or spread.
Hidden Mold and Mold Infestation Risks

Hidden mold is often far more dangerous than visible outbreaks. After water damage, mold grows behind walls, under floorboards, inside insulation, and in HVAC ducts where moisture lingers. Even without clear signs of mold, spores can concentrate and multiply, leading to a mold infestation that releases toxins and allergens throughout the home. Mold problems of this kind are challenging to spot but can be detected by persistent odors, unexplained health symptoms, or subtle property changes like soft drywall, peeling paint, or warped wood.
The risks associated with hidden mold include more than just property damage; they can impact indoor air quality and cause significant health issues. The longer mold is allowed to remain hidden, the more extensive (and expensive) the remediation process becomes. If you’ve experienced any water event and suspect hidden mold—even if you can’t see it—professional inspection is imperative for identifying and preventing further mold damage in your home.
Health Risks from Mold Growing After Water Damage

When mold growing after water damage goes unchecked, the health consequences can be severe. While some people experience only mild allergic reactions—such as sneezing, eye irritation, or skin rashes—prolonged exposure can exacerbate asthma attacks, trigger chronic respiratory symptoms, and put young children, the elderly, or those with compromised immune systems at extra risk. Mold exposure is most dangerous for infants, potentially causing coughing, wheezing, or more serious illnesses if the source isn’t eliminated quickly.
Symptoms of exposure may worsen as mold spores spread through HVAC or ventilation systems, contaminating the whole house. Immediate action to remove mold and eliminate water damage sources is the best way to protect the health of everyone in your home. If you notice family members consistently showing symptoms when indoors—especially after water problems—consider professional evaluation to address possible hidden mold.
Detecting Mold Problems After Water Damage
Recognizing Signs of Mold Growth in Your Home
Early detection of mold problems can mean the difference between a simple cleanup and a costly, invasive remediation project. The most obvious symptom is a persistent musty or earthy smell, even if there’s no visible mold. Other telltale signs include discoloration on walls, ceilings, carpets, and especially in places with recent or previous water damage. Watch out for flaking paint, soft or warped building materials, and visible black, green, or white patches. These signs of mold might be concentrated near sinks, basements, windows, or areas that have recently experienced a water leak or flood.
Don’t ignore household allergies that flare up indoors—this can indicate the early stages of a mold infestation affecting your indoor air. Homeowners who maintain vigilance for these indicators—and act quickly—are less likely to experience extensive mold damage or health problems over time. Being proactive is your best defense against hidden mold and lingering moisture.
Assessing the Affected Area and Extent of Mold Damage

Once you suspect mold, it’s important to thoroughly examine the affected area to determine the extent of the damage. Inspections should include visible surfaces as well as hidden or less obvious spots, such as behind baseboards, beneath carpets, in ceiling tiles, or inside cabinets. Specialized equipment, like moisture meters or thermal cameras, can help identify dampness that may not be detectable by touch alone. For large or persistent mold problems, or where inaccessible mold is suspected, many homeowners in Lexington, SC turn to professionals who can provide accurate, comprehensive assessments.
Proper assessment ensures that remediation can successfully remove mold and prevent it from returning. If mold damage is present in multiple rooms or on more than a few square feet, professional intervention is strongly recommended to avoid incomplete cleaning or health risks during DIY attempts. Early, thorough assessment is the first step toward safe, effective mold damage restoration after any water incident.
Mold Remediation: Steps to Remove Mold After Water Damage
- Identify the affected area
- Stop the source of water leak
- Dry out all wet surfaces fast
- Remove and dispose of mold-infested materials
- Use safe cleaning solutions for mold remediation
- Prevent mold from returning with proactive steps
Professional Mold Remediation vs. DIY Approaches
When it comes to mold remediation after water damage, homeowners are often faced with a choice: tackle the cleanup themselves or call in professionals. For isolated, minor cases (such as surface mold on tile or in a small restroom), DIY mold remediation can be effective if you use proper safety gear, remove all contaminated materials, and ensure the area is completely dry. However, large or hidden mold infestations—especially after significant water damage—require professional expertise and specialized equipment to ensure thorough containment, cleaning, and air quality restoration.
Professional mold remediation includes assessment, containment to prevent the spread of spores, removal of affected materials (like drywall or insulation), and the use of HEPA air scrubbers. Technicians then sanitize all surfaces, dry out hidden spaces, and perform after-cleaning inspections to verify success. DIY approaches often miss hidden mold or don’t address the root cause—such as unresolved humidity or a hidden water leak—leading to regrowth. For major or recurring mold problems, professional service is always the safer, more effective solution.
A step-by-step look at residential mold remediation: Technicians in full protective gear isolate the area, remove affected drywall, operate air scrubbers, and perform detailed inspections to ensure all mold is eliminated. Interviews with experts underscore the importance of acting quickly and thoroughly after water damage.
Mold Remediation Tips from Experts
These proven tips from Lexington, SC mold experts will help you stay ahead of mold problems after water damage:
- Act quickly. The faster you address water damage and dry out the area, the less likely mold will grow.
- Remove porous materials. Items like insulation, carpet pads, and ceiling tiles can’t be fully cleaned and should be discarded if contaminated.
- Protect yourself. Always wear gloves, goggles, and an N95 mask during cleanup to avoid mold exposure.
- Fix water sources first. Repair leaks or flooding issues before starting remediation—or mold will return.
- Use approved cleaning solutions. EPA-registered mold removers are safest and most effective for home use.
- Get a professional inspection if the affected area is larger than 10 square feet, if mold keeps returning, or if anyone has health issues.
Preventing Mold Growth After Water Damage
How to Prevent Mold After a Water Leak or Flood

The key to prevent mold after water damage is to dry out affected areas as quickly as possible. Immediately after a leak, burst pipe, or flood, extract any standing water and use high-powered fans and dehumidifiers to reduce humidity levels as quickly as possible. Open doors and windows to increase ventilation, and remove any rugs, upholstery, or personal belongings that have soaked up water. Clean and disinfect all hard surfaces with anti-mold products, paying special attention to baseboards, window sills, and HVAC returns.
Monitor humidity with inexpensive meters, aiming to keep the indoor level below 55%. Inspect your property regularly for slow drips, especially in attics, basements, and near water heaters or HVAC systems. Check around areas prone to roof leak or plumbing issues and maintain gutters to direct rainwater away from the foundation. Quick cleanup and vigilance are your strongest defenses for preventing a recurring mold problem after water damage.
Indoor Mold Prevention for Lexington, SC Residents
Living in a humid climate like Lexington, SC means that indoor mold prevention requires persistent attention. In addition to fast drying and leak repairs, regular maintenance of HVAC, dehumidifiers, and bathroom exhaust fans helps keep moisture in check year-round. Clean gutters, inspect for roof leak vulnerabilities, fix foundation cracks, and seal windows to keep both rain and humidity out.
Invest in waterproofing for below-grade spaces and use moisture-resistant materials (like tile and closed-cell insulation) during renovations. Schedule annual inspections—especially after heavy storms or hurricanes—so you can spot water damage early and prevent a mold to grow scenario. Educating family members about how to spot discoloration, musty odors, or areas of persistent dampness will help catch problems before they escalate, keeping your home safer and healthier.
Watch as a homeowner responds immediately after water damage: Water is extracted, dehumidifiers and fans are set up, surfaces are disinfected, and regular humidity checks are performed. The video highlights the importance of fast, proactive action to prevent future mold issues in Lexington, SC homes.
People Also Ask About Mold Growth After Water Damage
How to get rid of mold after water damage?
To effectively remove mold after water damage, first fix the source of moisture—whether that’s a leak or a flood. Then, dry out the affected area using fans and dehumidifiers. Remove all porous or mold-infested materials such as drywall, carpets, or insulation. Clean all hard surfaces with an EPA-approved cleaner. Wear protective gear throughout to minimize mold exposure. For larger or hidden mold growth, call a professional mold remediation service for a thorough cleanup and prevention plan.
Can mold make a baby cough?
Yes, mold exposure can make a baby cough and present other respiratory symptoms. Babies and young children are more vulnerable to allergic reactions from indoor mold, and exposure can lead to coughing, wheezing, and in some cases, more serious health problems. Keeping your living space dry and clean after water damage is critical to protecting babies and sensitive individuals from mold’s health effects.
What does mold look like after water damage?

After water damage, mold may appear as fuzzy or powdery patches in black, green, blue, or even white hues. It often grows in clusters and can be found on walls, ceilings, carpets, baseboards, and behind furniture. Sometimes, the only initial hint is a water line with slight discoloration or a musty aroma before more dramatic mold to grow is visible. If you notice any of these characteristics, act quickly to stop further damage.
Will mold go away if you stop a leak?
Halting the source of a water leak is essential and will prevent new mold from growing, but existing mold won’t just disappear. The affected area must be dried, cleaned, and any contaminated materials removed. If left untreated, dormant spores could reactivate with future moisture, leading to a recurring mold problem. It’s best to remediate visible mold immediately—even after fixing the leak.
Frequently Asked Questions: Dealing with Mold Growth After Water Damage
- How long does it take for mold to grow after water damage?
- Is it safe to stay in a home with visible mold growth?
- Does homeowners insurance cover mold remediation after water damage?
- Can mold return after remediation?
Key Takeaways on Mold Growth After Water Damage
- Mold growth after water damage can begin in as little as 24 to 48 hours.
- Always address water leaks and hidden mold immediately.
- Professional mold remediation ensures thorough mold removal and prevention.
- Preventing mold requires vigilance and quick action after any water disaster.
Conclusion: Fast Response Is Key to Stop Mold Growth After Water Damage
Don’t wait—acting rapidly after water damage is your best defense against mold growth, property loss, and health hazards.
Water Damage Repair in Lexington, SC – Get Professional Help Now
If you’re worried about mold growth after water damage in Lexington, SC, professional help is just a call away. The experts at Palmetto Mold Experts offer thorough inspections, rapid water damage restoration, and proven mold remediation services. Get Water Damage Repair In Lexington SC today—because your health, your home, and your peace of mind are worth it!
Sources
- https://www.epa.gov/mold/mold-cleanup-your-home – US EPA: Mold Cleanup in Your Home
- https://www.cdc.gov/mold/cleanup.htm – CDC: Mold Cleanup After Disasters
- https://palmettomoldexperts.com/lexington-sc-mold-removal/ – Palmetto Mold Experts: Lexington, SC Mold Remediation
Mold growth after water damage is a critical concern for homeowners, as mold can begin developing within 24 to 48 hours of moisture exposure. (servicemasterrestore.com) To effectively prevent mold, it’s essential to promptly remove excess water, thoroughly dry affected areas, and maintain indoor humidity levels below 60%. (moldzerollc.com) Regular inspections, especially in moisture-prone areas like basements and attics, can help detect early signs of mold, such as musty odors or discoloration. (baltimore.pauldavis.com) If mold is suspected or visible, consulting professional mold remediation services is advisable to ensure safe and thorough removal. (removewater.com)

